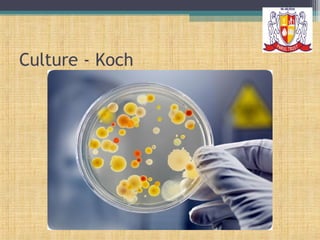
Culture - Koch

Microbiology is the study of microorganisms and their impact on human health, encompassing various subfields such as bacteriology and immunology. It highlights the importance of nurses having knowledge in microbiology to effectively manage patient care, especially in recognizing potential errors in treatment by physicians. Historical contributions from key figures in microbiology have led to advancements in disease understanding, diagnosis, and vaccination.